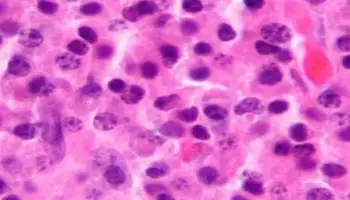

All malignant growth cells—even those inside a similar growth—contrast from one another and shift in the direction of malignant growth sickness. Researchers at Heidelberg College
Lithium-sulfur batteries (LSBs) have a greater capacity for energy storage. However, difficulties like as lithium polysulfides and lithium dendrite growth cause capacity loss and pose safety concerns. Researchers have created
With Amazon expecting to cause 10,000 conveyances with drones in Europe this year and Walmart wanting to extend its robot conveyance administrations to 60,000 extra homes this year in the
CRAM scientists at the College of Galway, along with associates at the Middle for Sub-atomic Nanometrology at the College of Strathclyde, have distributed work uncovering the inward functions of cells.
As of late, an exploration group has advanced an interesting way to deal with upgrading the effectiveness of solar-powered cells. Their emphasis on the potential antimony trisulfide (Sb2S3) as a